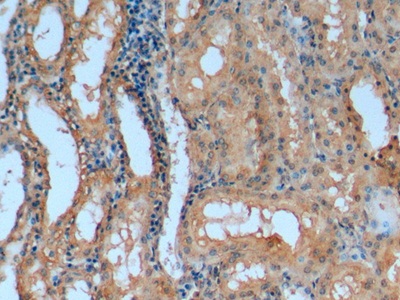

Monoclonal Antibody to Apolipoprotein A1 (APOA1)
Apo-A1; ApoA-1 Milano; ProapoA-I; Proapolipoprotein A-I; Truncated apolipoprotein A-I
- Product No.MAA519Po21
- Organism SpeciesSus scrofa; Porcine (Pig) Same name, Different species.
- SourceMonoclonal antibody preparation
- HostMouse
- Potency (Clone Number)C3
- Ig Isotype IgG2b Kappa
- PurificationProtein A + Protein G affinity chromatography
- LabelNone
- Immunogen RPA519Po01-Recombinant Apolipoprotein A1 (APOA1)
- Buffer Formulation0.01M PBS, pH7.4, containing 0.05% Proclin-300, 50% glycerol.
- TraitsLiquid
- Concentration1mg/mL
- Organism Species Moren/a
- ApplicationsWB; IHC
If the antibody is used in flow cytometry, please check FCM antibodies. - DownloadInstruction Manual
- UOM 20µl100µl 200µl 1ml 10ml
- FOB
US$ 119
US$ 279
US$ 398
US$ 995
US$ 3980
For more details, please contact local distributors!
SPECIFITY
The antibody is a mouse monoclonal antibody raised against APOA1. It has been selected for its ability to recognize APOA1 in immunohistochemical staining and western blotting.
USAGE
Western blotting: 0.01-3µg/mL;
Immunohistochemistry: 5-20µg/mL;
Optimal working dilutions must be determined by end user.
STORAGE
Store at 4°C for frequent use. Stored at -20°C in a manual defrost freezer for two year without detectable loss of activity. Avoid repeated freeze-thaw cycles.
STABILITY
The thermal stability is described by the loss rate. The loss rate was determined by accelerated thermal degradation test, that is, incubate the protein at 37°C for 48h, and no obvious degradation and precipitation were observed. The loss rate is less than 5% within the expiration date under appropriate storage condition.
GIVEAWAYS
INCREMENT SERVICES
-
 Antibody Labeling Customized Service
Antibody Labeling Customized Service
-
 Protein A/G Purification Column
Protein A/G Purification Column
-
 Staining Solution for Cells and Tissue
Staining Solution for Cells and Tissue
-
 Positive Control for Antibody
Positive Control for Antibody
-
 Tissue/Sections Customized Service
Tissue/Sections Customized Service
-
 Phosphorylated Antibody Customized Service
Phosphorylated Antibody Customized Service
-
 Western Blot (WB) Experiment Service
Western Blot (WB) Experiment Service
-
 Immunohistochemistry (IHC) Experiment Service
Immunohistochemistry (IHC) Experiment Service
-
 Immunocytochemistry (ICC) Experiment Service
Immunocytochemistry (ICC) Experiment Service
-
 Flow Cytometry (FCM) Experiment Service
Flow Cytometry (FCM) Experiment Service
-
 Immunoprecipitation (IP) Experiment Service
Immunoprecipitation (IP) Experiment Service
-
 Immunofluorescence (IF) Experiment Service
Immunofluorescence (IF) Experiment Service
-
 Buffer
Buffer
-
 DAB Chromogen Kit
DAB Chromogen Kit
-
 SABC Kit
SABC Kit
-
 Long-arm Biotin Labeling Kit
Long-arm Biotin Labeling Kit
-
 Real Time PCR Experimental Service
Real Time PCR Experimental Service
| Magazine | Citations |
| European Journal of Applied Physiology | Endurance training enhances ABCA1 expression in rat small intestine PubMed: 19629515 |
| Official Journal of the INWR | Effect of eight weeks of wrestling and circuit fitness training on Apo lipoportein A-I and lymphocyte ABCA1 gene expression in well-trained wrestler. Wrestling: source |
| Biochemical and Biophysical Research Communications | Treadmill exercise enhances ABCA1 expression in rat liver ScienceDirect: S0006291X0701488X |
| World Journal of Sport Sciences | The Effect of Eight Weeks of Wrestling and Wrestling Technique Based Circuit Training on Lymphocyte ABCA1 Gene Expression and Plasma Apolipoprotein A-1 Idosi: source |
| Biochimica et Biophysica Acta | Hepatic lipase- and endothelial lipase-deficiency in mice promotes macrophage-to-feces RCT and HDL antioxidant properties PubMed: 23328279 |
| Biomarkers | The association of a distinct plasma proteomic profile with the cervical high-grade squamous intraepithelial lesion of Uyghur women: a 2D liquid-phase chromatography/mass spectrometry study PubMed: 22458349 |
| Journal of the American Heart Association | MicroRNA-33 Deficiency Reduces the Progression of Atherosclerotic Plaque in ApoE?/? Mice PubMed: PMC3540673 |
| PLoS ONE | Apolipoprotein AI Is a Potential Mediator of Remote Ischemic Preconditioning Plosone: Source |
| Molecular Genetics and Metabolism | DYRK1A overexpression decreases plasma lecithin: cholesterol acyltransferase activity and apolipoprotein AI levels Pubmed: 23920041 |
| Endocrinology | Deficiency of Clusterin Exacerbates High-Fat Diet-Induced Insulin Resistance in Male Mice Pubmed: 24684302 |
| Molecular Genetics and Metabolism Reports | Corrective effects of hepatotoxicity by hepatic Dyrk1a gene delivery in mice with intermediate hyperhomocysteinemia Sciencedirect:S2214426915000026 |
| J Psychopharmacol | Anti-atherogenic properties of high-density lipoproteins in psychiatric patients before and after two months of atypical anti-psychotic therapy PubMed: 26253619 |
| Biochim Biophys Acta | Culturing of HepG2 cells with human serum improve their functionality and suitability in studies of lipid metabolism PubMed: 26515253 |
| Pharmacol Res Perspect | Efficacy of tomato concentrates in mouse models of dyslipidemia and cancer PubMed: 26171234 |
| Clin Exp Nephrol | Differentially expressed urinary biomarkers in children with idiopathic nephrotic syndrome PubMed: 26351173 |
| Oncogene | Apolipoprotein A-I inhibits experimental colitis and colitis-propelled carcinogenesis PubMed: 26279300 |
| Oncogene | Apolipoprotein AI inhibits experimental colitis and colitis-propelled carcinogenesis Pubmed:26279300 |
| Allergy | Serum levels of 9α,11β-PGF2 and apolipoprotein A1 achieve high predictive power as biomarkers of anaphylaxis. pubmed:28378321 |
| Journal of Chromatography A | Application of a new procedure for liquid chromatography/mass spectrometry profiling of plasma amino acid-related metabolites and untargeted shotgun proteomics to identify mechanisms and biomarkers of calcific aortic stenosis S0021967317311858 |
| 11 | High-Density Lipoproteins Exert Pro-inflammatory Effects on Macrophages via Passive Cholesterol Depletion and PKC-NF-kB/STAT1-IRF1 Signaling pubmed:27866837 |
| Biomedical Science Letters | Effect of Ginkgo biloba Extract (EGb 761) on Serum Cholesterol Levels in Wild-type C57Bl/6 Mice 10.15616/BSL.2017.23.2.80 |
| ACS Biomaterials Science & Engineering | Enhanced Antiatherosclerotic Efficacy of Statin-Loaded Reconstituted High-Density Lipoprotein via Ganglioside GM1 Modification abs:10.1021 |
| Food Research International | Wild Lonicera caerulea berry polyphenol extract reduces cholesterol accumulation and enhances antioxidant capacity in vitro and in vivo Pubmed:29580541 |
| Journal of The Science of Food and Agriculture | Consumption of orange fermented beverage improves antioxidant status and reduces peroxidation lipid and inflammatory markers in healthy humans Pubmed:29124773 |
| Toxicon | A membrane disrupting toxin from wasp venom underlies the molecular mechanism of tissue damage Pubmed:29654869 |
| European Journal of Pharmacology | The effect of exenatide (a GLP-1 analog) and sitagliptin (a DPP-4 inhibitor) on plasma platelet-activating factor acetylhydrolase (PAF-AH) activity and concentration in?… Pubmed: 30768981 |
| European Journal of Preventive Cardiology | High-intensity interval training has a greater effect on reverse cholesterol transport elements compared with moderate-intensity continuous training in obese male rats Pubmed: 31718266 |
| Diagnostics | Systemic Alterations of Immune Response-Related Proteins during Glaucoma Development in the Murine Model DBA/2J Pubmed: 32585848 |
| VETERINARY PATHOLOGY | Pathology and Proteomics-Based Diagnosis of Localized Light-Chain Amyloidosis in Dogs and Cats Pubmed: 32880234 |
| Nat Commun | GP73 is a TBC-domain Rab GTPase-activating protein contributing to the pathogenesis of non-alcoholic fatty liver disease without obesity 34853313 |
| Cardiovasc Toxicol | Interplay of Obesity, Ethanol, and Contaminant Mixture on Clinical Profiles of Cardiovascular and Metabolic Diseases: Evidence from an Animal Study Pubmed:35429258 |
| Peptides | Neuropeptide Y promotes hepatic apolipoprotein A1 synthesis and secretion through neuropeptide Y Y5 receptor Pubmed:35660638 |
| Journal of Functional Foods | Castanea mollissima shell polyphenols regulate JAK2 and PPARγ expression to suppress inflammation and lipid accumulation by inhibiting M1 macrophages … |